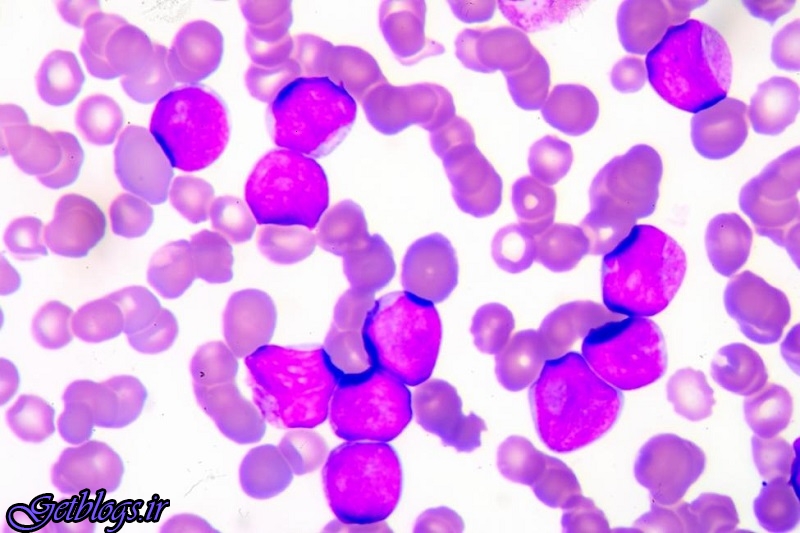
سلول های سرطانی با PH پایین ضعیف تر هستند

محققان موسسه تحقیقات زیست پزشکی بارسلونا واقع در اسپانیا دریافتند با کم کردن PH درونی سلول های سرطانی میزان و کیفیت تکثیر این سلول ها کم کردن می یابد.
سلول های سرطانی با PH پایین ضعیف تر هستند
عبارات مهم : محققان
به گزارش ایرنا از پایگاه خبری اسوشیتدپرس، نشانه محققان از این مطالعه که با استفاده از مدل های محاسباتی انجام شده است هست، درک بهتر ارتباط بین مسیرهای سوخت و ساز است که در محیط هایی با اسیدیته های متفاوت به کار گرفته می شوند و نشان دهنده مکانیزم های مورد استفاده سرطان جهت بقا در محیط های اسیدی است.
در مرحله بعدی محققان به بررسی میزان اسیدیته درون سلول ها پرداختند تا راهکارهایی را جهت اصلاح اثر روش های درمانی متداول بیابند.
سلول های سرطانی با PH پایین ضعیف تر هستند
محققان معتقدند از آنجا که در مرحله گسترش سرطان، آنزیم های متابولیک درون محیط های اسیدی بین سلولی عمل می کنند، این مولکول ها یک نشانه مناسب جهت روش های درمانی سرطان هستند. با استفاده از این روش تا کنون 5 نشانه بالقوه جهت درمان سرطان سینه در آزمایشگاه شناسایی شده است است.
برای انجام این تحقیقات، اطلاعات به دست آمده از آزمایشات بیوشیمیایی و بانک های اطلاعاتی مربوط به توصیف ژن های سلول های سرطانی مورد بررسی قرار داده شد و با استفاده از این اطلاعات یک مدل محاسباتی جهت مطالعه نحوه تاثیر میزان اسیدیته بر فعالیت حدود 2000 آنزیم متابولیک توسعه یافت.
محققان موسسه تحقیقات زیست پزشکی بارسلونا واقع در اسپانیا دریافتند با کم کردن PH درونی سلول های سرطانی میزان و کیفیت تکثیر این سلول ها کم کردن می یابد.
با وجود این که بخش عمده این تحقیقات نظری هست، محققان بر این باورند که بعضی از این اهداف آماده آزمایشات جانوری و ورود به مرحله آزمایشات مقدماتی هستند.
گزارش کامل این تحقیقات در نشریه Nature Communications انتشار یافته است.
سلول های سرطانی با PH پایین ضعیف تر هستند
واژه های کلیدی: محققان | تحقیقات | استفاده | درمان سرطان سینه | اخبار پزشکی
دانلود فایل ها
توجه: ممکن است تمام لینک های دانلود به دستور مقام قضایی حذف شده باشد...